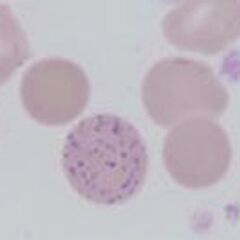
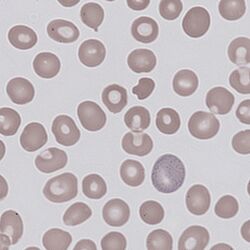
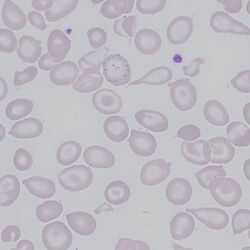

Basophilic stippling
From haematologyetc.co.uk
(punctate basophilia)
Derivation: mixed language: base [cationic] philien [to love] stippen [to prick]
Appearance
Multiple blue inclusions (generally >10) spread through the erythrocyte cytoplasm, these may be fine or coarse.
Images: Many fine blue dots are distributed fairly evenly throughout the erythrocyte cytoplasm. In contrast to other dot like inclusions the dots are very frequent (too many to count) and have similar though not identical size. The images show relatively fine stippling, but the appearance can be more coarse. Sometimes it is necessary to focus up and down with the microscope to see them clearly. Generally these cells are infrequent on any film.
Significance
Basophilic stippling most commonly arises when blood cell production is stressed or abnormal, so is important to look at clinical features and other morphology for clues (see causes. Although rare it is important to realise that basophilic stippling may be associated with dysfunction of enzymes involved in RNA breakdown (either congenital deficiency or drug induced) (see Pathogenesis).
Pitfalls
Basophilic stippling will rarely be confused with other inclusions due to their large number, and diffuse distribution. Occasionally Pappenheimer bodies (which can be multiple) can be confused, but Pappenheimer bodies are usually much fewer in number, tend not to have a uniform distribution, and typically have a grey/blue rather than pure blue colour. It is generally useful to distinguish fine (often reactive) from coarse (more frequently pathological) stippling.
Causes
| NORMAL INDIVIDUALS |
|---|
| Generally fine stippling – this may particularly be seen when there is an increased need for red cells e.g. during haemolysis, but also a range of reactive states |
| PATHOLOGICAL CAUSES |
| Generally coarse stippling. Two basic pathological processes may contribute to significant basophilic stippling in mature erythrocytes |
| Dyserythropoietic states |
| Infiltrated bone marrow: (look also for white cell precursor cells): consider leukaemia, myelofibrosis or infiltrating solid tumour. |
| Haemoglobinopathy (thalassaemia – most particularly haemoglobin H disease) |
| Dyserythropoiesis - particularly sideroblastic anaemias |
| Megaloblastic anaemias |
| Pathways of RNA breakdown are impaired |
| Poisoning (classically heavy metal, particularly lead, also consider arsenic) |
| Pyrimidine 5’ nucleotidase deficiency |
Clinical Examples
Clinical Image 1: A tear drop poikilocyte with prominent stippling, note the even distribution of many fine basophilic inclusions. Note also the large platelet and range of abnormal red cell forms. Clinical disorder: myelofibrosis.
Clinical Image 2: Fine basophilic stippling within a polychromatic erythrocyte. Note the many abnormal red cell forms in the background including irregularly contracted erythrocytes and one target cell; as well as absent platelets. Clinical disorder: myelodysplasia
Clinical Image 3: A further example of fine basophilic stippling within a polychromatic erythrocyte. Note that in this case the remaining erythrocytes are predominantly hypochromic and platelets are plentiful. Clinical disorder: thalassaemia
Pathobiology
Ribosomes are the cellular organelles the produce the haemoglobin protein in developing red cells. Ribosomes take up blue dyes, and therefore give the characteristic blue colour to immature erythrocytes or reticulocytes; when no longer required the ribosomes are removed by the spleen so mature red cells do not have any blue shading. Where red cell production is abnormal or stressed the ribosomes are retained in mature erythrocytes; these then form aggregates during the staining process causing these typical blue dots. A more specific cause is deficiency of the enzyme pyrimidine 5’nucleotidase – this failure impairs RNA breakdown causing ribosomes to be retained in mature cells. Lead or other heavy metal poisoning can also inhibit this enzyme causing stippling.